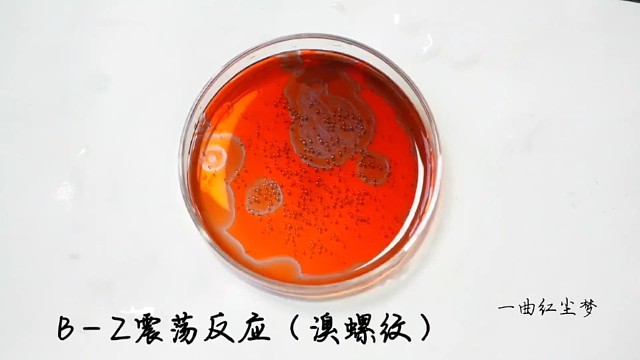
浪漫化学

-
00:13
我没想明白,是大气压、惯性还是虹吸原理呢?
-
05:47
如何判断一颗行星的类型
-
01:40
雷霄,就是个发热,为什么医生让做PETCT?
-
01:15
图扑软件粒子特效可视化展示
-
00:23
零基础学习也不是很难
-
00:29
浪漫化学
-
00:10
湖南郴州景区场地固化工程,土壤固化剂施工视频
-
01:08
天外来客月日一颗小行星将飞掠地球,小伙伴们看见了吗
-
00:19
有趣的物理
-
03:24
把蚊子幼虫泡在人类尿液里!会发生什么事?
-
01:01
SpaceX无人机船捕捉到猎鹰9号发射和着陆的壮丽景色,在天空划出一道银色天际线
-
02:45
忍者真的能在水中行走吗?实验结果出乎意料
-
00:12
这叫什么效应来着?
-
01:19
将岩浆倒在水气球上,会发生什么有趣的事情?
-
02:21
土拨鼠:当时我就报警了#俄罗斯小伙 #擦炮
-
02:13
渔网的工作原理是什么?下面明明是空的,为什么还能捕上来鱼?
-
00:09
还不能
-
01:57
一个关于“月亮”的故事,月球之谜!
-
03:21
一滴水里也可以藏着宇宙!关于浮游生物的你不知道的那些事#科学实验#知识科普#宇宙探索
-
00:13
00后大一新生用一年时间,自主研发火箭垂直起降飞控程序